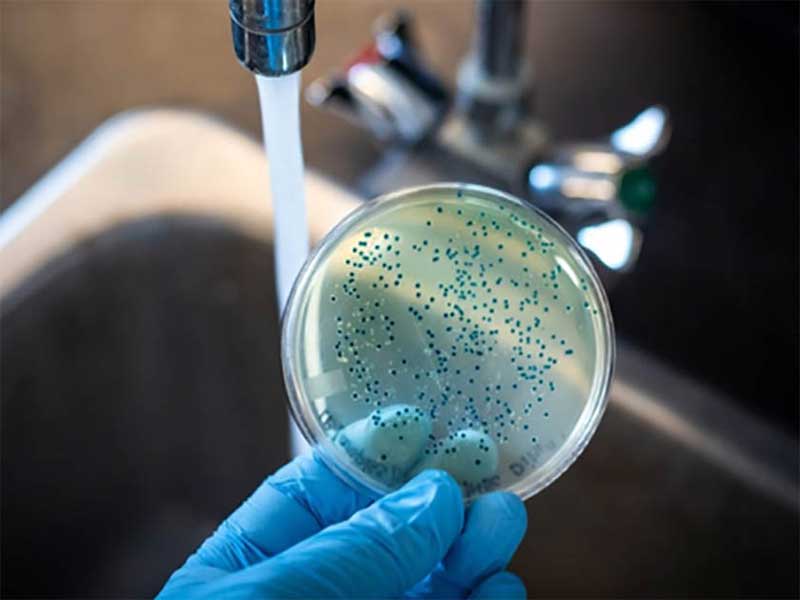

Trong bối cảnh môi trường ngày càng ô nhiễm, việc tiếp cận nguồn nước sinh hoạt an toàn đã trở thành thách thức lớn với nhiều hộ gia đình, khu dân cư và doanh nghiệp. Một trong những vấn đề thường gặp là nước sinh hoạt bị nhiễm vi khuẩn coliform – nhóm vi khuẩn chỉ thị cho tình trạng ô nhiễm phân và nước thải hữu cơ. Nếu không có giải pháp lọc nước sinh hoạt loại bỏ vi khuẩn coliform, nguy cơ bệnh tật lây truyền qua đường nước sẽ gia tăng, ảnh hưởng trực tiếp đến sức khỏe cộng đồng. Bài viết này sẽ giúp bạn hiểu rõ coliform là gì, tác hại ra sao và các công nghệ xử lý nước hiện đại loại bỏ hiệu quả vi khuẩn này.
Coliform là nhóm vi khuẩn có nguồn gốc từ đường ruột của người và động vật. Sự hiện diện của coliform trong nước sinh hoạt chứng tỏ nguồn nước đã bị ô nhiễm phân hoặc chất thải hữu cơ.
Theo QCVN 01-1:2024/BYT về chất lượng nước sinh hoạt, hàm lượng coliform phải đạt mức 0 MPN/100ml nước. Điều đó có nghĩa là nước cấp cho sinh hoạt không được phép chứa bất kỳ coliform nào. Đây là quy định bắt buộc nhằm bảo vệ sức khỏe người dân.
Nước sinh hoạt nhiễm coliform
Có nhiều nguyên nhân dẫn đến tình trạng nước sinh hoạt nhiễm vi khuẩn coliform, bao gồm:
Nếu không áp dụng biện pháp lọc nước sinh hoạt loại bỏ vi khuẩn coliform, người sử dụng có thể gặp nhiều rủi ro:
Đặc biệt, nhóm trẻ em, người già và người có hệ miễn dịch yếu dễ bị tác động nghiêm trọng hơn.

Tác hại của nước sinh hoạt chứa vi khuẩn coliform
Để xử lý coliform, nhiều công nghệ tiên tiến đã được áp dụng thành công:

Hệ thống lọc nước sinh hoạt loại bỏ vi khuẩn coliform
Việc lọc nước sinh hoạt loại bỏ vi khuẩn coliform không chỉ là yêu cầu bắt buộc để tuân thủ QCVN 01-1:2018/BYT, QCVN 01-1:2024/BYT, mà còn là giải pháp lâu dài để bảo vệ sức khỏe cộng đồng. Với sự phát triển của công nghệ, người dùng có thể lựa chọn nhiều phương án xử lý phù hợp từ hộ gia đình đến quy mô doanh nghiệp. Đầu tư vào hệ thống lọc nước đạt chuẩn không chỉ là giải pháp kỹ thuật, mà còn là cách xây dựng nền tảng sống an toàn, bền vững cho thế hệ hiện tại và tương lai.
Bạn đang cần tư vấn lắp đặt hệ thống lọc nước sinh hoạt, lọc nước đầu nguồn? Hãy liên hệ ngay với Công Nghệ Việt Phát để được hỗ trợ nhanh chóng và chính xác:
Công ty TNHH Thiết Bị Máy Và Công Nghệ Môi Trường Việt Phát
Công Nghệ Việt Phát – Giải pháp lọc nước công nghiệp đáng tin cậy cho doanh nghiệp Việt.
Công ty TNHH Thiết Bị Máy Và Công Nghệ Môi Trường Việt Phát
GPKD số 0105980275 do Sở KH và ĐT TP Hà Nội cấp ngày 27/08/2012
Địa chỉ ĐKKD: Số 36 ngách 65/5, tổ 18, Phường Phú Diễn, TP Hà Nội, Việt Nam
Địa chỉ sản xuất - Lắp ráp:
Điện thoại: 0932 333 299 – 0986 924 889
Email: congnghevietphat@gmail.com
Trạm lắp đặt và Bảo hành:
Đánh giá Lọc nước sinh hoạt loại bỏ vi khuẩn coliform – Giải pháp bảo vệ sức khỏe cộng đồng